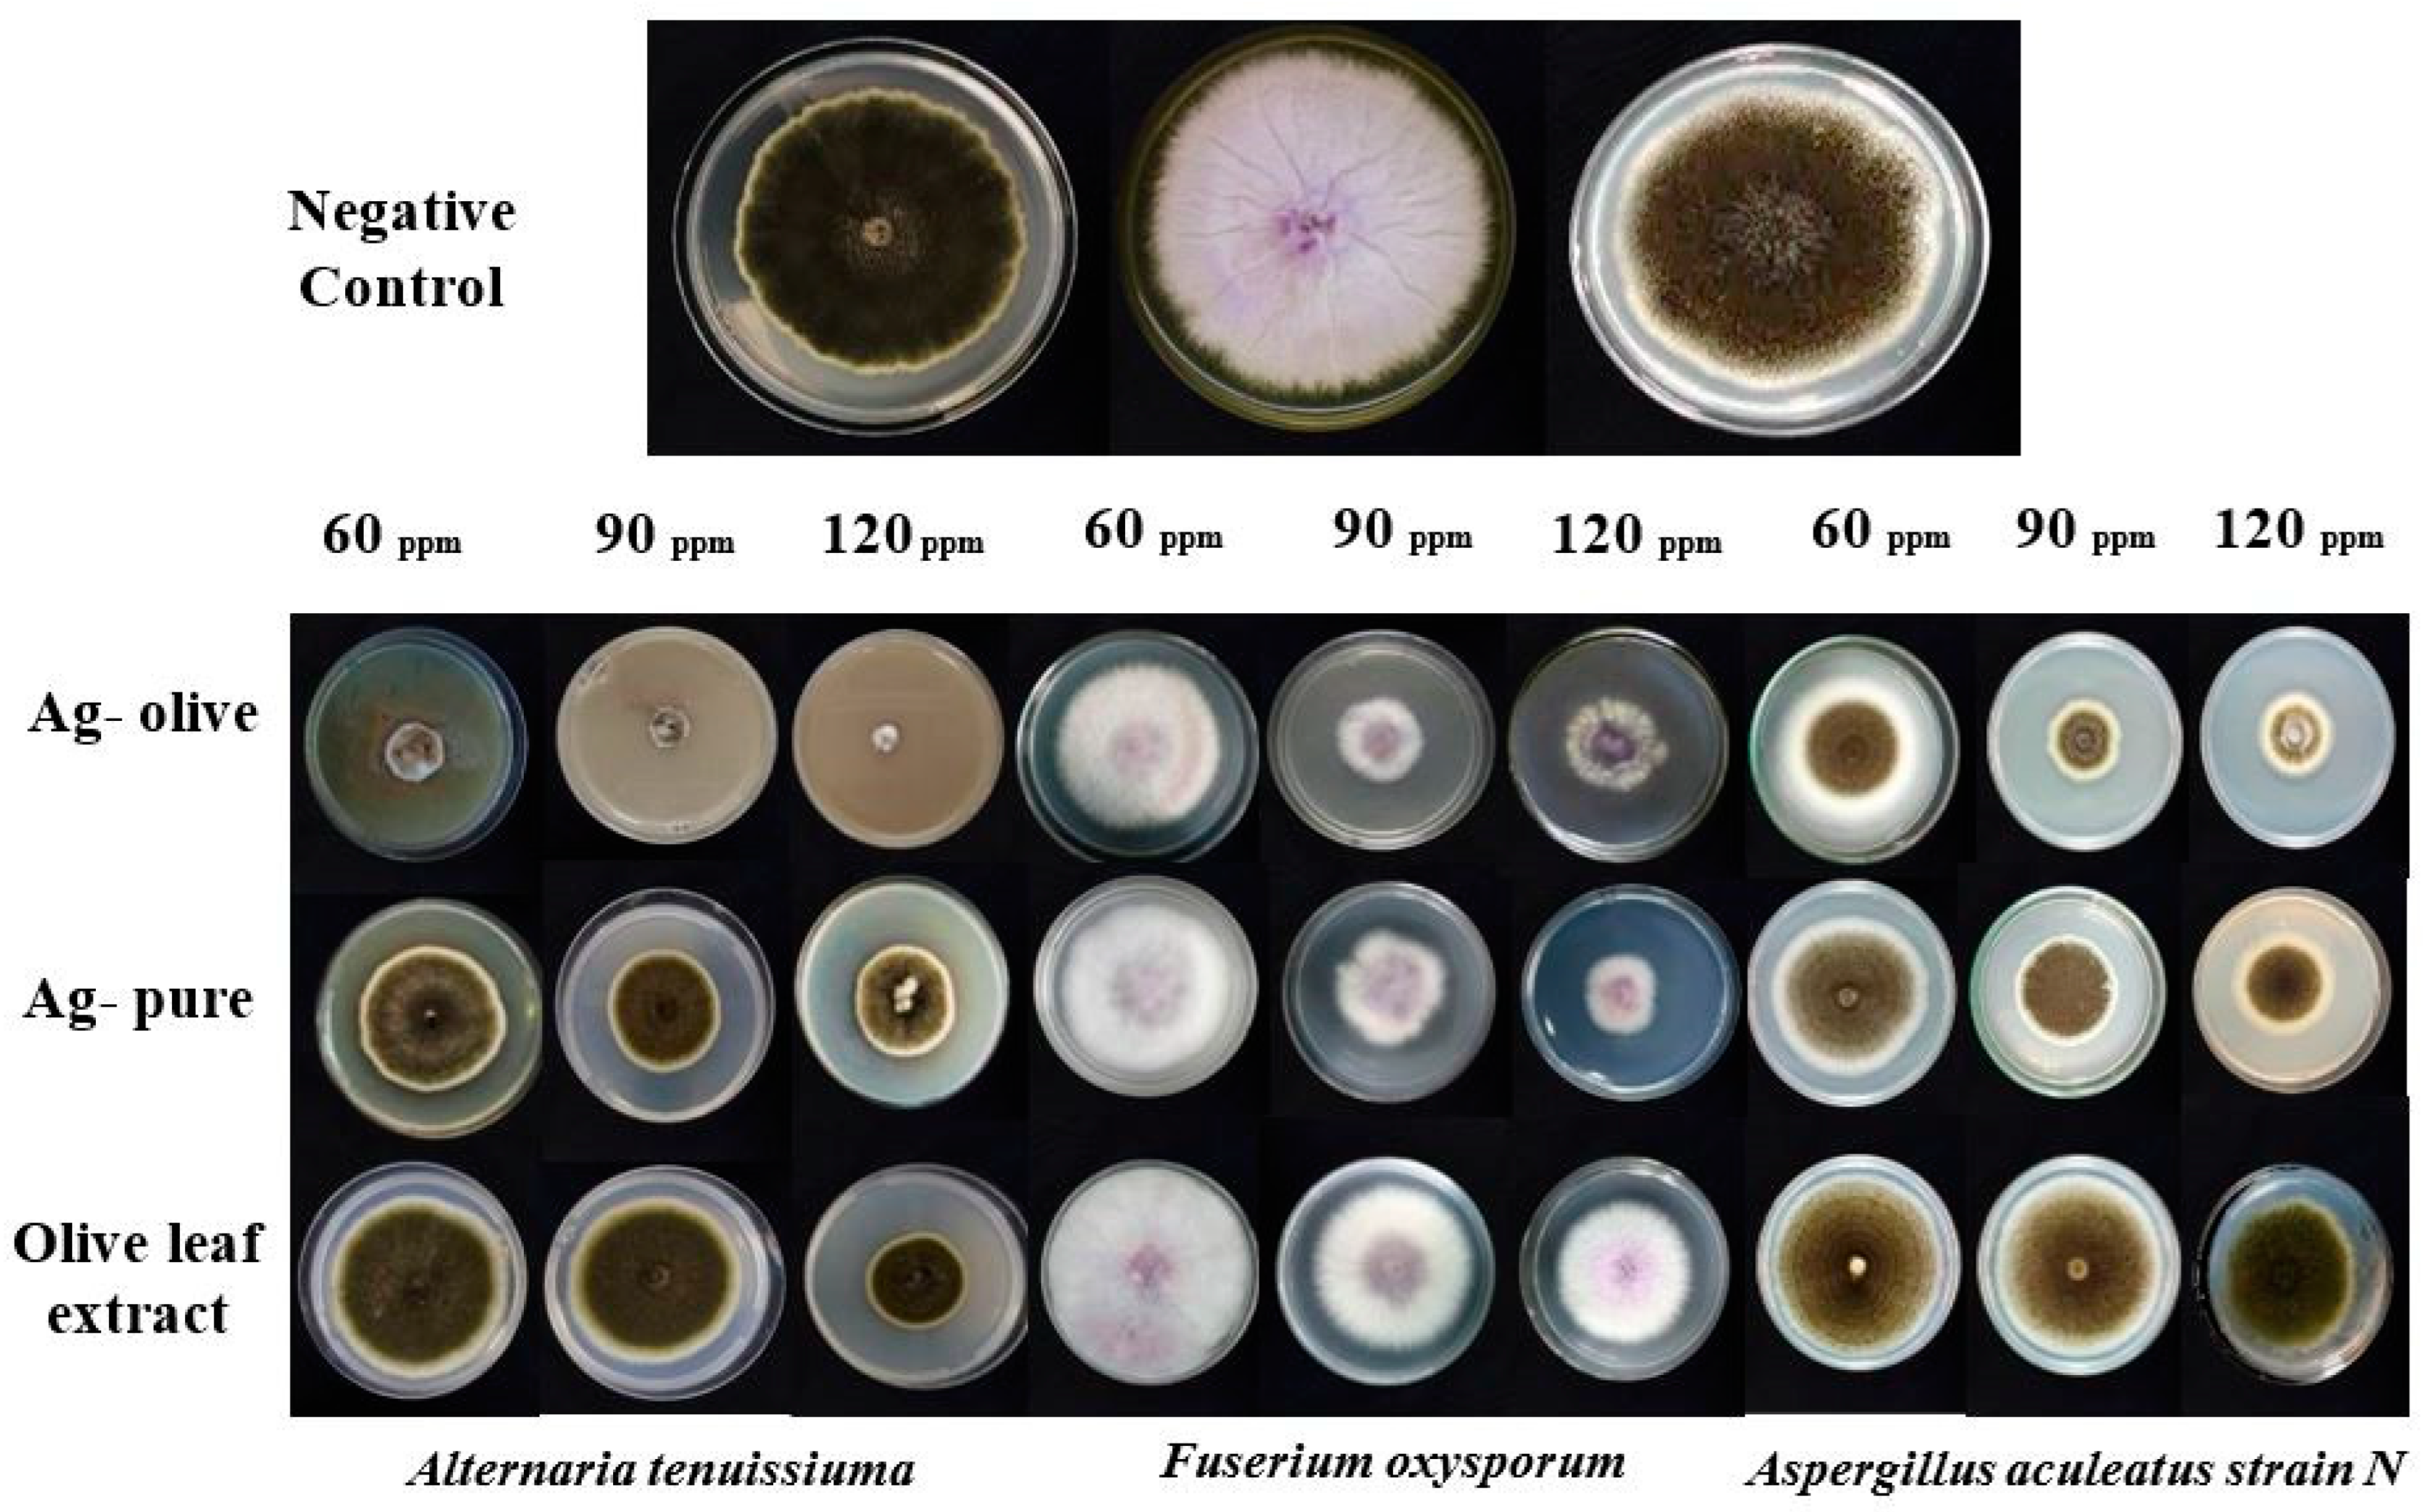
Ijms 25 03082 g007

Green Synthesis of Uncoated and Olive Leaf Extract-Coated Silver Nanoparticles: Sunlight Photocatalytic, Antiparasitic, and Antifungal Activities
Abstract
1. Introduction
2. Results and Discussion
2.1. Characterization
2.2. Antifungal Activity
2.3. Antiparasitic Activity
2.4. Photocatalytic Studies
3. Materials and Methods
3.1. Materials
3.2. Instruments
3.3. Preparation of Aqueous Extract of Olive Leaf
3.4. Synthesis of Ag-Olive and Ag-Pure
3.5. Antifungal Experiments
3.5.1. Solid Media
3.5.2. In liquid Media
3.6. Antiparasitic Activity Experiments
3.7. Data Analysis
3.8. Photocatalytic Activity
4. Conclusions
Author Contributions
Funding
Institutional Review Board Statement
Informed Consent Statement
Data Availability Statement
Conflicts of Interest
References
- Alqarni, L.S.; Alghamdi, M.D.; Alshahrani, A.A.; Nassar, A.M. Green Nanotechnology: Recent Research on Bioresource-Based Nanoparticle Synthesis and Applications. J. Chem. 2022, 2022, 4030999. [Google Scholar] [CrossRef]
- Alghamdi, M.D.; Nazreen, S.; Ali, N.M.; Amna, T. ZnO nanocomposites of Juniperus procera and Dodonaea viscosa extracts as antiproliferative and antimicrobial agents. Nanomaterials 2022, 12, 664. [Google Scholar] [CrossRef]
- Gong, D.; Celi, N.; Zhang, D.; Cai, J. Magnetic biohybrid microrobot multimers based on chlorella cells for enhanced targeted drug delivery. ACS Appl. Mater. Interfaces 2022, 14, 6320–6330. [Google Scholar] [CrossRef]
- Hussein, S.; Mahmoud, A.M.; Elgebaly, H.A.; Hendawy, O.M.; Hassanein, E.H.M.; Moustafa, S.M.N.; Alotaibi, N.F.; Nassar, A.M. Green Synthesis of Trimetallic Nanocomposite (Ru/Ag/Pd)-Np and Its In Vitro Antimicrobial and Anticancer Activities. J. Chem. 2022, 2022, 4593086. [Google Scholar] [CrossRef]
- Gong, D.; Sun, L.; Li, X.; Zhang, W.; Zhang, D.; Cai, J. Micro/Nanofabrication, Assembly, and Actuation Based on Microorganisms: Recent Advances and Perspectives. Small Struct. 2023, 4, 2200356. [Google Scholar] [CrossRef]
- Awiaz, G.; Lin, J.; Wu, A. Recent advances of Au@ Ag core–shell SERS-based biosensors. Exploration 2023, 3, 20220072. [Google Scholar] [CrossRef]
- Al-qarn, L.; Iqbal, Z. Surface-enhanced Raman spectroscopic sensing of glucose. Eur. Pharm. Rev. 2017, 22, 23–26. [Google Scholar]
- Shnoudeh, A.J.; Hamad, I.; Abdo, R.W.; Qadumii, L.; Jaber, A.Y.; Surchi, H.S.; Alkelany, S.Z. Synthesis, characterization, and applications of metal nanoparticles. In Biomaterials and Bionanotechnology; Elsevier: Amsterdam, The Netherlands, 2019; pp. 527–612. [Google Scholar]
- Zhang, X.F.; Liu, Z.G.; Shen, W.; Gurunathan, S. Silver nanoparticles: Synthesis, characterization, properties, applications, and therapeutic approaches. Int. J. Mol. Sci. 2016, 17, 1534. [Google Scholar] [CrossRef]
- Adnan, M. Synthesis, characterization and applications of endophytic fungal nanoparticles. Inorg. Nano-Met. Chem. 2020, 51, 280–287. [Google Scholar] [CrossRef]
- Hano, C.; Abbasi, B.H. Plant-based green synthesis of nanoparticles: Production, characterization and applications. Biomolecules 2021, 12, 31. [Google Scholar] [CrossRef]
- Yousefzadi, M.; Rahimi, Z.; Ghafori, V. The green synthesis, characterization and antimicrobial activities of silver nanoparticles synthesized from green alga Enteromorpha flexuosa (wulfen) J. Agardh. Mater. Lett. 2014, 137, 1–4. [Google Scholar] [CrossRef]
- Vijayan, R.; Joseph, S.; Mathew, B. Green synthesis, characterization and applications of noble metal nanoparticles using Myxopyrum serratulum AW Hill leaf extract. BioNanoScience 2018, 8, 105–117. [Google Scholar] [CrossRef]
- Din, M.I.; Rehan, R. Synthesis, characterization, and applications of copper nanoparticles. Anal. Lett. 2017, 50, 50–62. [Google Scholar] [CrossRef]
- Ganachari, S.V.; Yaradoddi, J.S.; Somappa, S.B.; Mogre, P.; Tapaskar, R.P.; Salimath, B.; Viswanath, V.J. Green Nanotechnology for Biomedical, Food, and Agricultural Applications; Springer International Publishing: Berlin/Heidelberg, Germany, 2019; Volume 4, pp. 2681–2698. [Google Scholar]
- Santhoshkumar, J.; Rajeshkumar, S.; Kumar, S.V. Phyto-assisted synthesis, characterization and applications of gold nanoparticles–A review. Biochem. Biophys. Rep. 2017, 11, 46–57. [Google Scholar] [CrossRef]
- Klaine, S.J.; Alvarez, P.J.; Batley, G.E.; Fernandes, T.F.; Handy, R.D.; Lyon, D.Y.; Lead, J.R. Nanomaterials in the environment: Behavior, fate, bioavailability, and effects. Environ. Toxicol. Chem. Int. J. 2008, 27, 1825–1851. [Google Scholar] [CrossRef]
- Zangeneh, M.M.; Bovandi, S.; Gharehyakheh, S.; Zangeneh, A.; Irani, P. Green synthesis and chemical characterization of silver nanoparticles obtained using Allium saralicum aqueous extract and survey of in vitro antioxidant, cytotoxic, antibacterial and antifungal properties. Appl. Organomet. Chem. 2019, 33, e4961. [Google Scholar] [CrossRef]
- Hirpara, D.G.; Hirpara, D.G.; Gajera, H.; Gajera, H. Green synthesis and antifungal mechanism of silver nanoparticles derived from chitin- induced exometabolites of Trichoderma interfusant. Appl. Organomet. Chem. 2019, 34, e5407. [Google Scholar] [CrossRef]
- Khalil, M.M.H.; Ismail, E.H.; El-Baghdady, K.Z.; Mohamed, D. Green synthesis of silver nanoparticles using olive leaf extract and its antibacterial activity. Arab. J. Chem. 2014, 7, 1131–1139. [Google Scholar] [CrossRef]
- Talhaoui, N.; Taamalli, A.; Gómez-Caravaca, A.M.; Fernández-Gutiérrez, A.; Segura-Carretero, A. Phenolic compounds in olive leaves: Analytical determination, biotic and abiotic influence, and health benefits. Food Res. Int. 2015, 77, 92–108. [Google Scholar] [CrossRef]
- Yang, L.; Ma, J.; Hou, C.; Lü, X.; Yan, H.; Kong, W.; Deng, Y. Evolution of phenotypic traits and main functional components in the fruit of ‘Chenggu-32′olives (Olea europaea L.) cultivated in longnan (China). J. Oleo Sci. 2020, 69, 973–984. [Google Scholar] [CrossRef] [PubMed]
- Žugčić, T.; Abdelkebir, R.; Alcantara, C.; Collado, M.C.; García-Pérez, J.V.; Meléndez-Martínez, A.J.; Barba, F.J. From extraction of valuable compounds to health promoting benefits of olive leaves through bioaccessibility, bioavailability and impact on gut microbiota. Trends Food Sci. Technol. 2019, 83, 63–77. [Google Scholar] [CrossRef]
- Pasković, I.; Lukić, I.; Žurga, P.; Majetić Germek, V.; Brkljača, M.; Koprivnjak, O.; Goreta Ban, S. Temporal variation of phenolic and mineral composition in olive leaves is cultivar dependent. Plants 2020, 9, 1099. [Google Scholar] [CrossRef] [PubMed]
- Alanazi, A.D.; Nguyen, V.L.; Alyousif, M.S.; Manoj, R.R.S.; Alouffi, A.S.; Donato, R.; Sazmand, A.; Mendoza-Roldan, J.A.; Dantas-Torres, F.; Otranto, D. Ticks and associated pathogens in camels (Camelus dromedarius) from Riyadh Province, Saudi Arabia. Parasites Vectors 2020, 13, 110. [Google Scholar] [CrossRef]
- Massoud, A.M.; A Kutkat, M.; Shafy, S.A.; El-Khateeb, R.M.; Labib, I.M. Acaricidal efficacy of Myrrh (Commiphora molmol) on the fowl tick Argas persicus (Acari: Argasidae). J. Egypt. Soc. Parasitol. 2005, 35, 667–686. [Google Scholar] [PubMed]
- Irache, J.M.; Esparza, I.; Gamazo, C.; Agüeros, M.; Espuelas, S. Nanomedicine: Novel approaches in human and veterinary therapeutics. Veter- Parasitol. 2011, 180, 47–71. [Google Scholar] [CrossRef]
- Alowaiesh, B.F.; Alhaithloul, H.A.S.; Saad, A.M.; Hassanin, A.A. Green Biogenic of Silver Nanoparticles Using Polyphenolic Extract of Olive Leaf Wastes with Focus on Their Anticancer and Antimicrobial Activities. Plants 2023, 12, 1410. [Google Scholar] [CrossRef]
- Sellami, H.; Khan, S.A.; Ahmad, I.; Alarfaj, A.A.; Hirad, A.H.; Al-Sabri, A.E. Green synthesis of silver nanoparticles using Olea europaea leaf extract for their enhanced antibacterial, antioxidant, cytotoxic and biocompatibility applications. Int. J. Mol. Sci. 2021, 22, 12562. [Google Scholar] [CrossRef]
- Rashidipour, M.; Heydari, R. Biosynthesis of silver nanoparticles using extract of olive leaf: Synthesis and in vitro cytotoxic effect on MCF-7 cells. J. Nanostructure Chem. 2014, 4, 112. [Google Scholar] [CrossRef]
- Irakli, M.; Chatzopoulou, P.; Ekateriniadou, L. Optimization of ultrasound-assisted extraction of phenolic compounds: Oleuropein, phenolic acids, phenolic alcohols and flavonoids from olive leaves and evaluation of its antioxidant activities. Ind. Crop. Prod. 2018, 124, 382–388. [Google Scholar] [CrossRef]
- Ghomari, O.; Sounni, F.; Massaoudi, Y.; Ghanam, J.; Kaitouni, L.B.D.; Merzouki, M.; Benlemlih, M. Phenolic profile (HPLC-UV) of olive leaves according to extraction procedure and assessment of antibacterial activity. Biotechnol. Rep. 2019, 23, e00347. [Google Scholar] [CrossRef]
- Abaza, L.; Taamalli, A.; Nsir, H.; Zarrouk, M. Olive tree (Olea europeae L.) leaves: Importance and advances in the analysis of phenolic compounds. Antioxidants 2015, 4, 682–698. [Google Scholar] [CrossRef]
- Nassar, A.M.; Zeid, E.F.A.; Elseman, A.M.; Alotaibi, N.F. A novel heterometallic compound for design and study of electrical properties of silver nanoparticles-decorated lead compounds. N. J. Chem. 2017, 42, 1387–1395. [Google Scholar] [CrossRef]
- Song, Y.; Yang, F.; Mu, B.; Kang, Y.; Hui, A.; Wang, A. Phyto-mediated synthesis of Ag nanoparticles/attapulgite nanocomposites using olive leaf extract: Characterization, antibacterial activities and cytotoxicity. Inorg. Chem. Commun. 2023, 151, 110543. [Google Scholar] [CrossRef]
- Alsohaimi, I.H.; Nassar, A.M.; Elnasr, T.A.S.; Cheba, B.A. A novel composite silver nanoparticles loaded calcium oxide stemming from egg shell recycling: A potent photocatalytic and antibacterial activities. J. Clean. Prod. 2019, 248, 119274. [Google Scholar] [CrossRef]
- Hassan, A.M.; Nassar, A.M.; Ibrahim, N.M.; Elsaman, A.M.; Rashad, M.M. An easy synthesis of nanostructured magnetite-loaded functionalized carbon spheres and cobalt ferrite. J. Coord. Chem. 2013, 66, 4387–4398. [Google Scholar] [CrossRef]
- Alharbi, N.S.; Alsubhi, N.S.; Felimban, A.I. Green synthesis of silver nanoparticles using medicinal plants: Characterization and application. J. Radiat. Res. Appl. Sci. 2022, 15, 109–124. [Google Scholar] [CrossRef]
- Sani, M.A.; Ehsani, A.; Hashemi, M. Whey protein isolate/cellulose nanofibre/TiO2 nanoparticle/rosemary essential oil nanocomposite film: Its effect on microbial and sensory quality of lamb meat and growth of common foodborne pathogenic bacteria during refrigeration. Int. J. Food Microbiol. 2017, 251, 8–14. [Google Scholar] [CrossRef] [PubMed]
- Patel, P.; Vadalia, J.; Butani, K.; Jadwani, K.; Mandal, N.K.; Khodaie, L. Green synthesis of silver nanoparticles, characterization and their biological efficacy. In Nanotechnology and In Silico Tools; Elsevier: Amsterdam, The Netherlands, 2024; pp. 117–139. [Google Scholar] [CrossRef]
- Nasir, G.A.; Mohammed, A.K.; Samir, H.F. Biosynthesis and Characterization of Silver Nanoparticles Using Olive Leaves Extract and Sorbitol. Iraqi J. Biotechnol. 2016, 15, 22–32. [Google Scholar]
- Hafeez, M.; Shaheen, R.; Akram, B.; Ahmed, M.N.; Ul-Abdin, Z.; Haq, S.; Din, S.U.; Zeb, M.; Khan, M.A. Green synthesis of nickel oxide nanoparticles using populus ciliata leaves extract and their potential antibacterial applications. South Afr. J. Chem. 2021, 75, 168–173. [Google Scholar] [CrossRef]
- Elsaesser, A.; Howard, C.V. Toxicology of nanoparticles. Adv. Drug Deliv. Rev. 2012, 64, 129–137. [Google Scholar] [CrossRef]
- Elechiguerra, J.L.; Burt, J.L.; Morones, J.R.; Camacho-Bragado, A.; Gao, X.; Lara, H.H.; Yacaman, M.J. Interaction of silver nanoparticles with HIV-1. J. Nanobiotechnology 2005, 3, 6. [Google Scholar] [CrossRef]
- Elmi, T.; Gholami, S.; Fakhar, M.; Azizi, F. A review on the use of nanoparticles in the treatment. J. Maz. Univ. Med. Sci. 2013, 23, 126–133. [Google Scholar]
- Zaheer, T.; Ali, M.M.; Abbas, R.Z.; Atta, K.; Amjad, I.; Suleman, A.; Khalid, Z.; Aqib, A.I. Insights into nanopesticides for ticks: The superbugs of livestock. Oxidative Med. Cell. Longev. 2022, 2022, 7411481. [Google Scholar] [CrossRef]
- Korbekandi, H.; Iravani, S.; Abbasi, S. Production of nanoparticles using organisms. Crit. Rev. Biotechnol. 2009, 29, 279–306. [Google Scholar] [CrossRef]
- Khadri, H.; Alzohairy, M.; Janardhan, A.; Kumar, A.P.; Narasimha, G. Green synthesis of silver nanoparticles with high fungicidal activity from olive seed extract. Adv. Nanoparticles 2013, 2, 241–246. [Google Scholar] [CrossRef]
- Kim, S.W.; Jung, J.H.; Lamsal, K.; Kim, Y.S.; Min, J.S.; Lee, Y.S. Antifungal effects of silver nanoparticles (AgNPs) against various plant pathogenic fungi. Mycobiology 2012, 40, 53–58. [Google Scholar] [CrossRef]
- Vazquez-Munoz, R.; Lopez, F.D.; Lopez-Ribot, J.L. Silver Nanoantibiotics display strong antifungal activity against the emergent multidrug-resistant yeast candida auris under both planktonic and biofilm growing conditions. Front. Microbiol. 2020, 11, 1673. [Google Scholar] [CrossRef] [PubMed]
- Vera-Reyes, I.; Altamirano-Hernández, J.; la Cruz, H.R.-D.; Granados-Echegoyen, C.A.; Loera-Alvarado, G.; López-López, A.; Garcia-Cerda, L.A.; Loera-Alvarado, E. Inhibition of phytopathogenic and beneficial fungi applying silver nanoparticles in vitro. Molecules 2022, 27, 8147. [Google Scholar] [CrossRef] [PubMed]
- Li, L.; Pan, H.; Deng, L.; Qian, G.; Wang, Z.; Li, W.; Zhong, C. The antifungal activity and mechanism of silver nanoparticles against four pathogens causing kiwifruit post-harvest rot. Front. Microbiol. 2022, 13, 988633. [Google Scholar] [CrossRef]
- Abdel-Ghany, H.S.M.; Abdel-Shafy, S.; Abuowarda, M.M.; El-Khateeb, R.M.; Hoballah, E.M.; Fahmy, M.M. Acaricidal Efficacy of Biosynthesized Zinc Oxide Nanoparticles Against Hyalomma dromedarii (Acari: Ixodidae) and Their Toxic Effects on Swiss Albino Mice. Acta Parasitol. 2022, 67, 878–891. [Google Scholar] [CrossRef]
- Allahverdiyev, A.; Abamor, E.; Bagirova, M.; Ustundag, C.B.; Kaya, C.; Rafailovich, M. Antileishmanial effect of silver nanoparticles and their enhanced antiparasitic activity under ultraviolet light. Int. J. Nanomed. 2011, 6, 2705–2714. [Google Scholar] [CrossRef]
- Ponarulselvam, S.; Panneerselvam, C.; Murugan, K.; Aarthi, N.; Kalimuthu, K.; Thangamani, S. Synthesis of silver nanoparticles using leaves of Catharanthus roseus Linn. G. Don and their antiplasmodial activities. Asian Pac. J. Trop. Biomed. 2012, 2, 574–580. [Google Scholar] [CrossRef]
- Zhang, C.; Xin, X.; Zhang, J.; Zhu, S.; Niu, E.; Zhou, Z.; Liu, D. Comparative evaluation of the phytochemical profiles and antioxidant potentials of olive leaves from 32 cultivars grown in China. Molecules 2022, 27, 1292. [Google Scholar] [CrossRef]
- Yaqoob, A.A.; Parveen, T.; Umar, K.; Mohamad Ibrahim, M.N. Role of nanomaterials in the treatment of wastewater: A review. Water 2020, 12, 495. [Google Scholar] [CrossRef]
- Alsohaimi, I.H.; Alotaibi, N.F.; Albarkani, A.M.; Chen, Q.; Moustafa, S.M.; Alshammari, M.S.; Nassar, A.M. Photocatalytic wastewater treatment and disinfection using green ZnO-NP synthesized via cera alba extract. Alex. Eng. J. 2023, 83, 113–121. [Google Scholar] [CrossRef]
- Shimi, A.K.; Ahmed, H.M.; Wahab, M.; Katheria, S.; Wabaidur, S.M.; Eldesoky, G.E.; Rane, K.P. Synthesis and applications of green synthesized TiO2 nanoparticles for photocatalytic dye degradation and antibacterial activity. J. Nanomater. 2022, 2022, 7060388. [Google Scholar] [CrossRef]
- Alqarni, L.S.; Alghamdi, M.D.; Alshahrani, A.A.; Alotaibi, N.F.; Moustafa, S.M.; Ashammari, K.; Nassar, A.M. Photocatalytic Degradation of Rhodamine-B and Water Densification via Eco-Friendly Synthesized Cr2O3 and Ag@Cr2O3 Using Garlic Peel Aqueous Extract. Nanomaterials 2024, 14, 289. [Google Scholar] [CrossRef]
- Fardood, S.T.; Forootan, R.; Moradnia, F.; Afshari, Z.; Ramazani, A. Green synthesis, characterization, and photocatalytic activity of cobalt chromite spinel nanoparticles. Mater. Res. Express 2020, 7, 015086. [Google Scholar] [CrossRef]
- Fouda, A.; Awad, M.A.; Al-Faifi, Z.E.; Gad, M.E.; Al-Khalaf, A.A.; Yahya, R.; Hamza, M.F. Aspergillus flavus-mediated green synthesis of silver nanoparticles and evaluation of their antibacterial, anti-candida, acaricides, and photocatalytic activities. Catalysts 2022, 12, 462. [Google Scholar] [CrossRef]
- Moustafa, S.M.N.; Taha, R.H.; Abdelzaher, H.M.A.; Elgebaly, H.A. Novel biosynthesis of Ag-nanocomplex for controlling Verticillium wilt disease of olive tree. Arch. Phytopathol. Plant Prot. 2021, 55, 198–216. [Google Scholar] [CrossRef]
- Marimuthu, S.; Rahuman, A.A.; Rajakumar, G.; Santhoshkumar, T.; Kirthi, A.V.; Jayaseelan, C.; Bagavan, A.; Zahir, A.A.; Elango, G.; Kamaraj, C. Evaluation of green synthesized silver nanoparticles against parasites. Parasitol. Res. 2010, 108, 1541–1549. [Google Scholar] [CrossRef] [PubMed]

| Fungal Strain | Mycelium Growth Inhibition (%) | ||||||||
|---|---|---|---|---|---|---|---|---|---|
| Olive Leaf Extract | Ag-Pure | Ag-Olive | |||||||
| 60 ppm | 90 ppm | 120 ppm | 60 ppm | 90 ppm | 120 ppm | 60 ppm | 90 ppm | 120 ppm | |
| Alternaria tenuissiuma | 0 | 0 | 50 ± 0.2 | 12.5 ± 0.1 | 50 ± 0.2 | 50 ± 0.5 | 62 ± 0.1 | 75 ± 0.3 | 88.7 ± 0.1 |
| Aspergillus aculeatus strain N | 0 | 5.8 ± 0.1 | 29.4 ± 0.5 | 29.4 ± 0.3 | 47.1 ± 0.1 | 52.9 ± 0.2 | 41.2 ± 0.1 | 64.7 ± 0.1 | 64.7 ± 0.2 |
| Fuserium oxysporum | 0 | 17.6 ± 0.2 | 29.4 ± 0.1 | 5.8 ± 0.1 | 41.2 ± 0.3 | 64.7 ± 0.2 | 29.4 ± 0.4 | 64.7 ± 0.2 | 64.7 ± 0.3 |
| Fungal Species | Control | Olive Leaf Extract | Ag-Pure | Ag-Olive | ||||||
|---|---|---|---|---|---|---|---|---|---|---|
| 0 ppm | 60 ppm | 90 ppm | 120 ppm | 60 ppm | 90 ppm | 120 ppm | 60 ppm | 90 ppm | 120 ppm | |
| Alternaria tenuissiuma | 2.8 | 1.21 | 0.72 | 0.51 | 1.00 | 0.57 | 0.50 | 140 | 0.53 | 0.50 |
| Aspergillus aculeatus strain N | 2.5 | 1.39 | 1.21 | 0.91 | 1.30 | 0.96 | 0.81 | 1.00 | 0.56 | 0.51 |
| Fuserium oxysporum | 3 | 1.91 | 0.84 | 0.87 | 1.83 | 0 | 0 | 1.83 | 0 | 0 |
| Nanomaterial | Bioactivity | Effect | Reference |
|---|---|---|---|
| Ag-NPs | Antifungal | The green synthesis of AgNPs from olive seed extract is strong enough to destroy harmful fungus, including Aspergillus niger, which causes human aspergillosis. | [48] |
| Ag-NPs | Antifungal | AgNPs had antifungal effects at different doses against these plant diseases. Most fungi were completely inhibited after treatment with WA-CV-WB13R AgNPs. According to the results, PDA and 100 ppm of AgNPs demonstrated the greatest suppression of plant-harmful fungus. | [49] |
| Ag-NPs | Antifungal | The findings show that AgNPs have substantial anti-C. auris action in both planktonic and biofilm growth environments, suggesting that AgNPs might help reduce infections brought on by this new nosocomial danger. | [50] |
| Ag-NPs | Antifungal | Maximum degrees of growth inhibition were observed at 60 ppm for Alternaria solani and Botrytis cinerea (70.76% and 51.75%, respectively). Similar to this, Macrophomina spp. required 120 ppm of silver nanoparticles to produce 65.43% suppression, but Fusarium oxisporum only required 39.04% at the same dose. | [51] |
| Ag-NPs | Antifungal | The findings demonstrate that four kiwifruit rot pathogens, namely Alternaria alternata, Pestalotiopsis microspora, Diaporthe actinidiae, and Botryosphaeria dothidea, were successfully reduced by 75 ppm AgNPs in terms of both mycelial development and spore germination. | [52] |
| Ag-NPs | Antifungal | The antimicrobial efficacy against Alternaria tenuissiuma, Aspergillus japonicus var. aculeatus, and Fuserium oxysporum was as-prepared (Ag-olive) > Ag-pure > olive leaf extract. | This work |
| Ag-NPs | Antiparasitic | Inhibited larvae of malaria vector, Anopheles subpictus Grassi | [53] |
| Ag-NPs | Antiparasitic | inhibited the growth and metabolic activity of promastigotes, hence preventing Leishmania tropica and its antileishmanial effects. | [54] |
| Ag-NPs | Antiparasitic | Showed antiplasmodial activity against P. falciparum. | [55] |
| Ag-NPs | Antibacterial | The multidrug-resistant strains of S. aureus, P. aeruginosa, and E. coli were strongly suppressed by the AgNPs at a dosage of 0.03–0.07 mg/mL. | [20] |
| Olive leaves | Antioxidant | High values for the tests of the ferric reducing/antioxidant powers. | [56] |
| Ag-olive | Antifungal | High antifungal activity against Aspergillus japonicas, Aculeatus Fuserium oxysporum and Alternaria tenuissiuma | This work |
| Antiparasitic | Strong inhibitory effect against mature ticks (Hyalomma dromedarii). (Acari: Ixodidae) |
| Catalyst | Light Source | Dye Concentration | Catalyst Dose | % Degradation | Time (min) | Ref. |
|---|---|---|---|---|---|---|
| ZnO-NPs, green method | Sunlight | 10 ppm MB | 1 g/L | 100 | 40 | [58] |
| TiO2-NPs, green method | UV lamp | 10 ppm MB | 10 mg/100 mL | 96 | 120 | [59] |
| Cr2O3-NPs, green method | Sunlight | 5 ppm RhB | 0.8 g/L | 97.5 | 60 | [60] |
| CoCr2O4-NPs, green method | Visible light | 20 ppm EBT | 40 mg/50 mL | 90 | 90 | [61] |
| Ag-NPs, green method | 250-Watt halogen lamp | 10 ppm MB | 70 mg/30 mL | 86.4 | 200 | [62] |
| Ag-NPs, green method | Sunlight | 5 ppm of RhB, MB, and EBT | 20 mg/50 mL | 96%, 95%, and 85% for RhB, MB, and EBT, respectively. | 5 | This work |
Disclaimer/Publisher’s Note: The statements, opinions and data contained in all publications are solely those of the individual author(s) and contributor(s) and not of MDPI and/or the editor(s). MDPI and/or the editor(s) disclaim responsibility for any injury to people or property resulting from any ideas, methods, instructions or products referred to in the content. |
© 2024 by the authors. Licensee MDPI, Basel, Switzerland. This article is an open access article distributed under the terms and conditions of the Creative Commons Attribution (CC BY) license (https://creativecommons.org/licenses/by/4.0/).
Share and Cite
Alotaibi, N.F.; ALqarni, L.S.; Alghamdi, S.Q.; Al-Ghamdi, S.N.; Amna, T.; Alzahrani, S.S.; Moustafa, S.M.; Hasanin, T.H.; Nassar, A.M. Green Synthesis of Uncoated and Olive Leaf Extract-Coated Silver Nanoparticles: Sunlight Photocatalytic, Antiparasitic, and Antifungal Activities. Int. J. Mol. Sci. 2024, 25, 3082. https://doi.org/10.3390/ijms25063082
Alotaibi NF, ALqarni LS, Alghamdi SQ, Al-Ghamdi SN, Amna T, Alzahrani SS, Moustafa SM, Hasanin TH, Nassar AM. Green Synthesis of Uncoated and Olive Leaf Extract-Coated Silver Nanoparticles: Sunlight Photocatalytic, Antiparasitic, and Antifungal Activities. International Journal of Molecular Sciences. 2024; 25(6):3082. https://doi.org/10.3390/ijms25063082
Chicago/Turabian StyleAlotaibi, Nasser F., Laila S. ALqarni, Samia Q. Alghamdi, Sameera N. Al-Ghamdi, Touseef Amna, Soad S. Alzahrani, Shaima M. Moustafa, Tamer H. Hasanin, and Amr Mohammad Nassar. 2024. "Green Synthesis of Uncoated and Olive Leaf Extract-Coated Silver Nanoparticles: Sunlight Photocatalytic, Antiparasitic, and Antifungal Activities" International Journal of Molecular Sciences 25, no. 6: 3082. https://doi.org/10.3390/ijms25063082
APA StyleAlotaibi, N. F., ALqarni, L. S., Alghamdi, S. Q., Al-Ghamdi, S. N., Amna, T., Alzahrani, S. S., Moustafa, S. M., Hasanin, T. H., & Nassar, A. M. (2024). Green Synthesis of Uncoated and Olive Leaf Extract-Coated Silver Nanoparticles: Sunlight Photocatalytic, Antiparasitic, and Antifungal Activities. International Journal of Molecular Sciences, 25(6), 3082. https://doi.org/10.3390/ijms25063082

